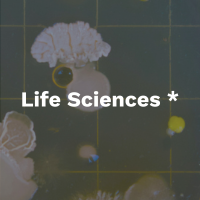
13

Our Flagship Program: The Activate Fellowship
Join a community that transforms groundbreaking research into real world impact
Our Flagship Program: The Activate Fellowship
Support and training for scientists to launch a successful hard tech science startup
Activate's two-year U.S. fellowship program transforms scientists and engineers into founders, empowering them to reinvent the world by bringing their research to market.
We provide early-stage science entrepreneurs with funding, technical resources, and unparalleled support from a network of scientists, engineers, investors, commercial partners, and fellow entrepreneurs.
We’ve taken 294 scientists from zero to one, helping them start 235 impactful, hard tech science companies.
Explore our applicant criteria and process
Meet Activate Fellows and explore their companies.
The Activate Advantage. All for zero equity
A fellowship designed to integrate community, resources, and opportunity.
Funding
More than $300K over two years to provide an annual living stipend, R&D, and other common living expenses.
Community
A network of peers, alumni, and advisors who collaborate and celebrate each other's successes.
Education
Leadership development including workshops, virtual trainings and skill-building sessions.
Mentorship
Regular 1:1s with our community team members to provide guidance and unbiased advice.

Our Managing Directors are at the heart of each community.
As former science entrepreneurs, they've faced the challenges of turning research into impact.
They understand the highs and lows of the journey and are uniquely equipped to help fellows navigate the complexities of building hard tech ventures.
Work locally, connect nationally.
Activate Anywhere allows fellows to remain embedded in their local innovation ecosystems while accessing Activate’s national network of mentorship, education, and resources. This flexible model, sponsored by the National Science Foundation, ensures that fellows can build impactful ventures wherever they are.
A scientist by training, See has extensive hard tech experience at the intersection of startups and corporates. He spent over a decade at Lux Research building new verticals and research products, gaining extensive experience in emerging technology strategy and evaluating disruptive startups in energy, materials, robotics, and AI. Subsequently, he led product strategy at Geminus, an industrial AI startup, setting strategic direction and building valuable partnerships. Before transferring to his current role, he served as Head of Ecosystem for Activate, where he mentored fellows on commercialization and leveraged the network to connect them with mentors, advisors, customers, and partners.
Kevin See
Managing Director | Activate Anywhere
Activate Berkeley: At the heart of innovation.
Activate Berkeley, in partnership with Cyclotron Road at Lawrence Berkeley National Laboratory, offers access to Berkeley’s research ecosystem and the Bay Area’s thriving innovation hub. Fellows benefit from world-class research facilities, a collaborative environment, and proximity to top-tier investors and partners.
Fuss spent 20 years at Lawrence Berkeley National Laboratory (Berkeley Lab) researching the structural biology and molecular mechanisms of DNA repair enzymes. During her time at Berkeley Lab, she co-founded Cinder Biological, Inc., a biotech company, and was an Activate Fellow in the 2018 cohort. Fuss has a Ph.D. in molecular and cell biology from U.C. Berkeley and a B.A. in environmental science from Wesleyan University.
Jill Fuss
Managing Director | Activate Berkeley
Activate Boston: Where science meets opportunity.
Activate Boston is situated in one of the world’s most renowned innovation hubs, home to groundbreaking research in biotech, defense, energy, and microelectronics. Fellows here are part of a dynamic community that bridges academia, industry, and government.
Recht shares his decade of startup executive experience, including leading his own startup to acquisition, with Activate Boston Fellows. He has brought high-impact technologies to market in the fields of hydrogen storage, AI infrastructure, and 3D printing. Recht holds a Ph.D. in applied physics from Harvard University and a B.A. in physics from Princeton University.
Dan Recht
Managing Director | Activate Boston
Activate Houston: Leading innovation in energy and beyond.
Houston, the global energy capital, is rapidly becoming a leader in the energy transition. Activate Houston fellows are at the forefront of developing technologies that drive sustainability and innovation in energy and beyond.
Pitts has nearly 20 years of experience in energy and sustainability, including as the CTO at a startup where he developed technology that could eliminate wellhead methane emissions from legacy oil and gas assets. Before moving to Houston, Pitts co-founded Greentown Labs in Boston and worked at a solar startup. He holds an M.B.A. from the MIT Sloan School of Management, an M.S. in mechanical engineering from MIT, and a bachelor’s degree in mechanical engineering from Caltech.
Jeremy Pitts
Managing Director | Activate Houston
Activate New York: Innovation that never sleeps.
Activate New York collaborates with NYSERDA and Columbia University to provide fellows with access to cutting-edge resources, training, and a global network. Fellows here are part of a vibrant ecosystem driving impact across diverse industries.
A scientist and two-time founder, Escoda brings experience across venture building and investing in hard tech. She has founded companies in payments SaaS and quantum computing hardware, and later served as a venture capital GP, raising and managing Seed and fund vehicles. She began her career at D. E. Shaw & Co., developing a data-driven approach to investing. Over the past 15+ years, she has built and advised deep-tech ventures, with experience spanning university tech transfer, product strategy, and supporting founders across fintech, AI, biotech, and advanced computing.
Cristina Escoda
Managing Director | Activate New York




.png)
Driving Innovation Across Sectors
Activate supports 16 verticals, aligned with our broader mission to meet the urgency of global challenges
-

Integrating robotics,
advanced materials
processing,
real-time sensing
and controls,
production automation,
and next-generation
supply chains.
-

Advancing the
design, materials,
and efficiency of
the infrastructure
we live and work in.
-

Developing tools
for capture,
utilization, storage,
and verification of
carbon and other
radiative-forcing gases.
-

Redefining chemistry
and materials through
advanced processes,
sustainable technologies,
and novel compounds.
-

Developing better and
longer-lasting alternatives,
efficient substitutes,
sustainable upgrades,
and adaptions to
a changing world.
-

Pioneering computer
technologies, including
semiconductors,
quantum computing,
AI, advanced storage,
and high-throughput
systems.
-

Advancing technologies
for sustainable extraction,
energy, and management
of Earth’s resources.
-

Transforming electronics
through advances
in MEMS, RF, IoT,
hardware, sensors,
and interfaces.
-

Reimagining power
generation, grids, and
energy delivery across
renewables, combustion,
storage, and efficiency.
-

Enhancing batteries and
storage technologies to
capture and deploy
power effectively.
-

Improving yields,
resilience, and
sustainability across
agriculture and
food systems.
-

Innovating industrial
biotechnology through
microbes, fermentation,
enzymes, and
bio-derived chemicals.
-
Advancing genetics,
genomics, metabolomics,
and precision health
technologies.
-

The next generation
of satellites, rockets,
planes, drones, UAVs,
orbital/landing tech,
engine dynamics, and
remote sensing
-

Connecting our world
across the land and sea
through autonomy,
electric motors,
EV batteries,
trains, boats, drones,
logistics, and
supply chains.
-

Designing technologies
to improve the quality,
availability, and use
of water.
*If you are a potential applicant, see our FAQ titled, “Are all life science applications eligible? What about innovations in healthcare?” before deciding to apply.
Fueling the Future of Science and Innovation
The Activate Fellowship is made possible through the generous support of our funding sponsors, including philanthropic organizations, government agencies, and private sector partners. Their commitment to advancing science and technology enables us to empower the next generation of leaders and bring groundbreaking innovations to life.


